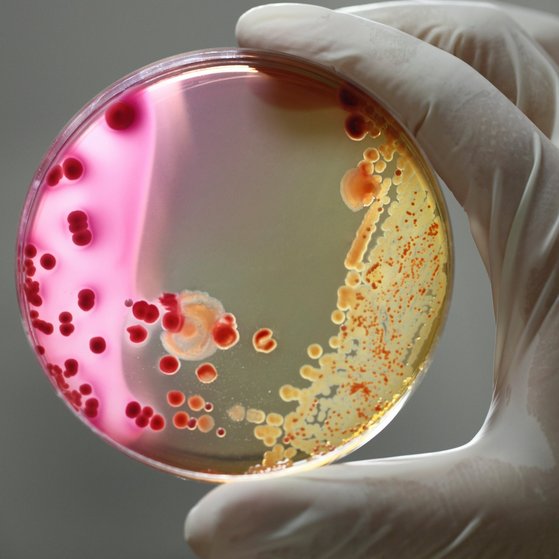
Agarschale wird mit zwei Fingern hochgehalten.

Gesundheitliche Bewertung von Bakterien
Bakterien sind Mikroorganismen, die nur aus einer einzigen Zelle bestehen. Sie kommen überall in unserem Körper und in der Umwelt vor.
Unsere Themen zu Bakterien
Im Gegensatz zu Viren können sich Bakterien selbst vermehren. Sie teilen sich in der Mitte und bilden eigenständige Zellen. Dieser Vorgang wird als Bakterienwachstum oder Vermehrung bezeichnet.
Auch nützliche Bakterien können gefährlich werden
Viele Bakterien sind für den Menschen lebensnotwendig, etwa solche, die verhindern, dass sich Krankheitserreger zu stark vermehren. Manchmal können aber auch nützliche Bakterien zu Krankheitserregern werden und eine Infektion auslösen. Solche Infektionen sind bei Menschen mit geschwächtem Immunsystem möglich oder wenn Bakterien, z.B. über Wunden, in unseren Körper eindringen.
Was macht das BfRkurz fürBundesinstitut für Risikobewertung?
Das BfRkurz fürBundesinstitut für Risikobewertung bewertet Risiken, die durch krankmachende Bakterien in Lebensmitteln entstehen. Solche Bakterien können zum Beispiel aufgrund von Hygienemängeln bei der Lebensmittelproduktion oder direkt aus dem landwirtschaftlichen Bereich in Lebensmittel gelangen. Solche mikrobiellen Krankheitserreger, die vom Tier auf den Mensch übertragen werden, nennt man Zoonosenerreger. Krankheiten, die vom Tier auf den Menschen übergehen können, bezeichnet man folglich als Zoonosen.